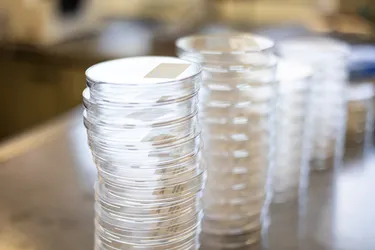
Petrischalen im Wasserlabor

Wasserlabor stellt Trinkwasser auf die Probe
Rund 2.300 Kilometer – mehr als die Strecke von Hannover bis ins norwegische Hammerfest, allgemeinhin als die nördlichste Stadt Europas bekannt: So lang ist das weitverzweigte Trinkwasser-Rohrnetz von enercity. Im Normalbetrieb fließen hier rund 6 Millionen Liter pro Stunde durch, um die 700.000 Menschen in Hannover und in den umliegenden Gemeinden mit der wertvollen Ressource zu versorgen. Im Durchschnitt ist das frische Wasser etwa einen Tag vom Werk bis zu den Wasserhähnen unterwegs. Und jeder Tropfen, der aus der Leitung kommt – ob zum Duschen, Kochen oder Blumengießen – darf durchaus mit dem Prädikat „Premiumprodukt“ beschrieben werden. Denn die Qualität des Wassers aus den enercity-Wasserwerken wird strengstens überwacht.
„Regelmäßige mikrobiologische Analysen dienen der Kontrolle der Wasserqualität”, erklärt Dr. Saskia Brandt. Die Biologin leitet das als unabhängige Untersuchungsstelle akkreditierte Wasserlabor von enercity. Hier bearbeiten acht Mitarbeitende im 7-Tage-Betrieb Wasserproben, bewerten die Ergebnisse und erstellen Prüfberichte.
Das Wasser von enercity stammt aus vier unterschiedlichen Quellen: aus den Wasserwerken in Elze-Berkhof, Fuhrberg und Grasdorf sowie aus den Harzwasserwerken. „Das an die Hannoveraner:innen gelieferte Wasser hat jedoch immer die von der Trinkwasserverordnung vorgeschriebene Qualität“, so Brandt weiter. Ergebnis der engmaschigen Kontrolle: Das Trinkwasser von enercity unterschreitet die strengen Grenzwerte der Verordnung deutlich und weist ein ausgewogenes Mineralienverhältnis auf.

7.000 Wasserproben im Jahr
Regelmäßig werden Proben in den Werken und über das gesamte Rohrnetz verteilt entnommen. Der Ablauf einer Probeentnahme und die Untersuchung wird nach strengen DIN-Vorschriften geregelt, erklärt Prüfleiterin Antje Nord. „Die Probenehmer:innen vom Wasserlabor liefern die zuvor geplanten und protokollierten Wasserproben im Labor ab“, so Nord, „hier starten die Kolleg:innen mit den mikrobiologischen Untersuchungen nach Bakterien – standardmäßig sind das unter anderem E.coli Bakterien, die zu Magen-Darmbeschwerden führen können.“ Je nach Bedarf werde das Wasser auch auf Keime wie Enterokokken untersucht, die im Trinkwasser ein Indiz für fäkale Verunreinigungen sind. Alle durchgeführten mikrobiologischen Analysen liefern Ergebnisse, die im Rahmen des Qualitätsmanagements abgesichert und den Kund:innen auf transparente Weise zur Verfügung gestellt werden.

Warum arbeitet das formell zu enercity gehörende Wasserlabor eigentlich für andere Kund:innen? „In Niedersachsen gibt es nur wenige Wasserlabore, die rechtlich anerkannte mikrobiologische Trinkwasser-Untersuchungen in dieser Form durchführen dürfen“, erklärt Leiterin Brandt. Sie betont das Kriterium der Unabhängigkeit des Labors – um diese zu gewährleisten, sind von der zuständigen Deutschen Akkreditierungsstelle unter anderem externe Aufträge von privaten, öffentlichen und gewerblichen Kund:innen gefordert. Das Labor besitzt unter anderem durch langjährige Mitarbeiter:innen, die 365 Tage im Jahr für Kund:innen ansprechbar sind, über eine ausgewiesene Expertise – rund 7.000 Proben führt das Wasserlabor im Jahr durch.
„Das eigentlich wertvollste dieses Labors sind die hier arbeitenden Menschen, die als Team wunderbar harmonieren“, unterstreicht Brandt. Die Kooperationen mit anderen Laboren zeigen, dass es schwer ist, die eigenen hohen Standards zu erfüllen – die im enercity-Wasserlabor sei von Schnelligkeit, Flexibilität und einem hohen Qualitätsanspruch geprägt. Es mache sich in der Branche bemerkbar, dass Fachpersonal fehle – umso wichtiger ist es für das Team, eigenen Nachwuchs ausbilden zu können. Eine wichtige Investition in Menschen, damit auch in Zukunft jeder Trinkwassertropfen, der durch die 2.300 Kilometer lange Rohrleitung bis zu den Wasserhähnen fließt, maximal gesichert ist. So, wie es enercity seit mehr als 100 Jahren tut.
enercity beliefert rund 700.000 Kund:innen der Landeshauptstadt Hannover, Langenhagen, Seelze, Laatzen, Teile von Ronnenberg, Hemmingen und Pattensen mit frischem Trinkwasser. Im Mittel kommen rund 90 Prozent des Trinkwassers kommen aus den eigenen Wasserwerken - Elze-Berkhof, Fuhrberg und Grasdorf. Etwa 9 Prozent des Wassers stammt aus den Harzwasserwerken.
Sie möchten regelmäßig über innovative Technologien und spannende Fakten rund um die Themen Energie und Klimaschutz informiert werden? Dann abonnieren Sie den Newsletter unseres Energiemagazins #positiveenergie!